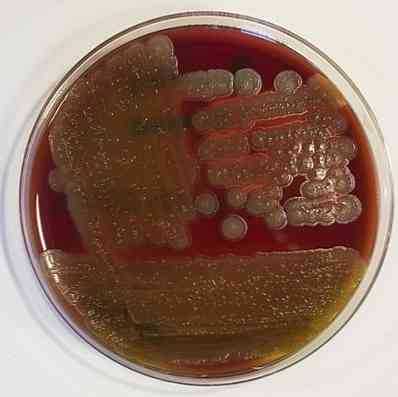

Bacillus cereus. Морфология bacillus cereus. Культуральные свойства bacillus cereus. Клиника отравлений bacillus cereus. Принципы микробиологической диагностики bacillus cereus. Выявление bacillus cereus.
Добавил пользователь Alex Обновлено: 08.01.2026
Впервые этиологическая роль Bacillus cereus при пищевых отравлениях была изучена и описана Hauge в 1950 г.
Сначала источником пищевых отравлений, обусловленных Вас. cereus, считали кулинарные изделия, содержащие картофельный крахмал. Затем были описаны вспышки пищевых отравлений этой этиологии, обусловленные растительными, мясными, мясо-растительными, рыбными и другими пищевыми продуктами. Особенно быстро Вас. cereus размножается в измельченных продуктах (фарш, котлеты, колбаса, кремы). При накоплении этого микроба изменяются органолептические свойства продукта: на поверхности образуется сероватая пленка, изменяются цвет и запах.
Одни исследователи из-за отсутствия возбудителя в испражнениях и короткого инкубационного периода (6—14 ч) определяли пищевые отравления, вызванные Вас. cereus, как интоксикации, другие же это связывали с антагонизмом кишечной микрофлоры и отсутствием специальных питательных сред для выделения Вас. cereus. Некоторым исследователям удалось выделить Вас. cereus из испражнений больных, используя среды, содержащие спирт.
В последнее время патогенез пищевых отравлений, обусловленных Вас. cereus, объясняют следующим образом. Считают, что в результате выделения этим микробом фермента лецитиназы образуются продукты расщепления лецитина (фосфохолин и пр.), оказывающие токсическое действие на организм. Кроме того, при парентеральном заражении мышей была отмечена высокая патогенность штаммов Вас. cereus, выделенных при пищевых отравлениях, и установлено наличие термостабильного энтеротропного и термолабильного нейротропного токсина.
Количественный фактор в возникновении пищевых отравлений, вызванных Вас. cereus, имеет такое же значение, как и при отравлениях, обусловленных кишечной палочкой.
Морфология . Вас. cereus — палочка длиной 8 мкм, шириной 0,9—1,5 мкм, подвижная, образует споры. Отдельные штаммы этого микроба могут образовывать капсулу. Грамположительная.
Культуральные свойства . Вас. cereus — аэроб, но может развиваться и при недостатке кислорода воздуха. На МПА вырастают крупные, распластанные, серовато-беловатые колонии с изрезанными краями, некоторые штаммы образуют розовато-коричневый пигмент; на кровяном агаре — колонии с широкими, резко очерченными зонами гемолиза; на МПБ — образует нежную пленку, пристеночное кольцо, равномерное помутнение и хлопьевидный осадок на дне пробирки. Все штаммы Вас. cereus интенсивно растут при рН от 9 до 9,5; при рН 4,5—5 прекращают свое развитие. Оптимальная температура развития 30—32°С, максимальная 37—48°С, минимальная 10°С.
Ферментативные свойства . Вас. cereus свертывает и пептонизирует молоко, вызывает быстрое разжижение желатина, способен образовывать ацетилметилкарбинол, утилизировать цитратные соли, ферментирует мальтозу, сахарозу. Некоторые штаммы способны расщеплять лактозу, галактозу, дульцит, инулин, арабинозу, глицерин. Маннит не расщепляет ни один штамм.
Устойчивость . Вас. cereus относится к микроорганизмам, чрезвычайно широко распространенным в природе. Основной средой его обитания является почва. Лучше Вас. cereus развивается в почвах с нейтральной или слабощелочной реакцией. Из почвы микроб попадает в воздух и водоемы, на пищевые продукты. Размножение начинается при 17—18°С, наиболее интенсивно — при 32°С. Вас. cereus часто обнаруживают в пастеризованном молоке (до 86%. исследованных проб), в консервах (до 11,6%) и др. Микроб может развиваться при концентрации поваренной соли в среде до 10-15%, сахара —до 30—60%. Продукты с рН 4,5 и ниже являются неблагоприятной средой для развития Вас. cereus. На жизнедеятельность Вас. cereus кроме рН влияет и вид кислоты. Наибольшим бактериостатическим действием обладает уксусная кислота. Задержка роста Вас. cereus этой кислотой наблюдается при рН 4,5 и даже 6,0. Подкисление продуктов другими кислотами задерживает рост только при рН 4,0.
Патогенность . При заражении белых мышей большими дозами Вас. cereus они погибают. В то же время он непатогенен в отличие от Вас. anthracis для морских свинок и кроликов. Вас. cereus выделяет фермент лецитиназу, являющийся фактором вирулентности. Наличие этого микроорганизма в продуктах может вызывать пищевые отравления. Вас. cereus может вызвать мастит у коров.
Диагностика . Учитывая количественный фактор в патогенезе пищевых отравлений, вызываемых Вас. cereus на первом этапе микробиологического исследования проводят микроскопию мазков (окраска мазков по Граму). Наличие в мазках грамположительных палочек толщиной 0,9 мкм позволяет поставить ориентировочный диагноз: «споровый аэроб группы 1а». По современной классификации в группу 1а входят Вас. anthracis и Вас. cereus. При выяснении этиологии пищевых отравлений большое значение имеет дифференциация Вас. cereus и Вас. anthracis, так как кишечная форма сибирской язвы, вызываемая Вас. anthracis, по клиническим признакам может быть принята за пищевое отравление.
Второй этап микробиологического исследования проводят в том случае, если количество обнаруженных при микроскопии палочек достигает в 1 г продукта 10 8 .
Затем, по результатам микроскопии патологический материал высевают на кровяной агар в чашки Петри и инкубируют при 37°С в течение 1 сут. Наличие широкой, резко очерченной зоны гемолиза позволяет поставить предварительный диагноз на присутствие Вас. cereus. Для окончательной идентификации производят посев выросших колоний в среду Козера и углеводную среду с маннитом. Ставят пробу на лецитиназу, ацетилметилкарбинол и проводят дифференциацию Вас. anthracis и других представителей рода Bacillus. Вас. anthracis отличается от Вас. cereus рядом характерных признаков: рост в бульоне и желатине, способность образовывать капсулу в организмехи на средах, содержащих кровь или кровяную сыворотку.
Кроме вышеописанных методов применяют экспресс-методы дифференциации Вас. anthracis от Вас. anthracoides, Вас. cereus и других: феномен «ожерелья», пробу с сибиреязвенным бактериофагом, реакцию преципитации — и проводят люминесцентную микроскопию. Можно использовать также цитопатогенный эффект фильтрата Вас. cereus на клетки культур тканей (фильтрат Вас. anthracis такого эффекта не оказывает).
От других сапрофитных споровых аэробов Вас. cereus отличается по ряду свойств: способность образования лецитиназы, ацетилметилкарбинола, утилизация цитратных солей, ферментация маннита и рост в анаэробных условиях на среде с глюкозой. Особенно важное значение придают лецитиназе.
Образование на кровяном агаре зон гемолиза не является постоянным признаком у Вас. cereus. так как некоторые штаммы и разновидности Вас. cereus (например, Var. sotto) не вызывают гемолиза эритроцитов, в то время как многие другие виды споровых аэробов обладают этим свойством.
Bacillus cereus таксономия, характеристика, морфология, среда обитания
Bacillus cereus Это бактерия, принадлежащая к роду Bacillus, способная вырабатывать токсины. Хотя это часто изучалось, это еще не полностью известно, оставаясь определенными аспектами, которые будут обнаружены.
Им удалось выделить образцы Bacillis cereus во многих средах, таких как почва, вода, некоторые растения и даже в кишечнике некоторых животных. Из этого можно сделать вывод, что эта бактерия способна выживать в очень разнообразных и широкомасштабных условиях..

Важность изучения этой бактерии заключается в том, что она связана с определенными патологиями, главным образом желудочно-кишечного тракта. Благодаря своей способности выживать, он может преобладать в еде даже после приготовления пищи и заражения людей..
- 1 Таксономия
- 2 Характеристики
- 2.1 Это грамположительная бактерия
- 2.2 Факультативно-анаэробный
- 2.3 Это мезофил
- 2.4 Имеет разнообразный обмен веществ
- 2.5 Это каталаза положительная
- 2.6 Выжить в широком диапазоне рН
- 2.7 Это бета-гемолитическая бактерия
- 2.8 Производит споры
- 6.1 рвотный синдром
- 6.2 Диарейный синдром
- 6.3 Кератит
- 6.4 Панофтальмит
- 6.5 Эндофтальмит
таксономия
Чтобы выяснить особенности и биологическое поведение организма, необходимо знать его таксономию. В случае Bacillus cereus, Это следующее:
домен: Бактерии
фила: Firmicutes
класс: бациллы
заказ: Bacillales
семья: Bacillaceae
жанр: бацилла
вид: B. cereus
черты
![]()
Bacillus cereus - это бактерия, имеющая медицинское значение из-за патогенного действия токсинов, которые она производит. Среди его наиболее выдающихся биологических характеристик:
Это грамположительная бактерия
Посевы Bacillus cereus при воздействии процесса окрашивания по Граму они приобретают фиолетовую окраску. Это неоспоримое доказательство присутствия пептидогликана в его клеточной стенке, в который попадают частицы красителя.
Факультативно-анаэробный
Bacillus cereus может развиваться оптимально в средах, богатых кислородом, а также при его отсутствии. Благодаря этому он может адаптироваться к самым разнообразным средам.
Однако тип среды обитания, в которой этот микроорганизм лучше всего развивается, - это среда, в которой есть кислород. Это так по двум причинам. Во-первых, для получения одного из двух типов токсинов, которые он производит, требуется кислород..
Вторая причина заключается в том, что экспериментально было продемонстрировано, что в отсутствие кислорода скорость роста этой бактерии снижается..
Он мезофил
Мезофильный организм - это тот, который оптимально и эффективно развивается в промежуточных температурных диапазонах. В случае Bacillus cereus, оптимальный интервал теплового роста составляет от 30 ° C до 40 ° C.
Обладает разнообразным метаболизмом
В зависимости от условий окружающей среды и наличия питательных веществ, Bacillus cereus Может бродить несколько типов соединений. Среди них можно упомянуть глюкозу, глицерин, салицин и сахарозу.
В дополнение к этому он способен метаболизировать нитраты, превращая их в нитриты.
Это положительный результат каталазы
Bacillus cereus содержит фермент каталазу, который позволяет ему разворачивать молекулу перекиси водорода в воде и кислороде.
Выжить в широком диапазоне рН
PH является параметром, который относится к степени кислотности или щелочности. В случае бактерий Bacillus cereus, может выжить в средах с pH от 4,9 до 9,3.
Это означает, что он легко адаптируется к слабокислой и слабощелочной среде. При нейтральном рН они поддерживаются эффективно.
Это бета-гемолитическая бактерия
Bacillus cereus Это бактерия, которая обладает способностью вызывать гемолиз в эритроцитах. Это может быть подтверждено при проведении культивирования в агаризованной среде, обогащенной кровью..
Производит споры
Споры - это клетки, из которых могут генерироваться новые бактерии. Они представляют собой своего рода стационарную фазу в жизненном цикле Bacillus cereus.
Споры этой бактерии характеризуются высокой устойчивостью к изменениям окружающей среды, а также к таким физическим факторам, как гамма-излучение..
морфология
Bacillus cereus Это типичная бактерия из группы бацилл, с характерной формой стержня с квадратными концами. В посевах можно увидеть как прямые или немного изогнутые.
Они также могут быть индивидуальными или образующими короткие струны. Средний размер каждой бактериальной клетки составляет 1 х 3-4 мкм, и они имеют жгутики, равномерно распределенные по всей их поверхности..
С генетической точки зрения, они содержат одну кольцевую хромосому, которая имеет 5481 генов, которые в свою очередь кодируют в общей сложности 5234 белка.
среда обитания
Один из самых выдающихся аспектов Bacillus cereus Это его повсеместность. Это означает, что его можно найти в различных средах. Все это благодаря его способности выживать в различных условиях окружающей среды pH и температуры.
Благодаря различным исследованиям удалось выделить штаммы этой бактерии как в полярных почвах, так и в тропических местах, что подтверждает ее способность заселять разнообразные природные среды..
Их можно найти в почвах, растениях, минеральных водах, отложениях и даже пыли.
Болезни, которые он производит
Bacillus cereus Это патогенная бактерия, которая может вызывать множество патологий у людей: инфекции желудочно-кишечного тракта и за его пределами, а также, в крайних случаях, системные инфекции.
Эта бактерия производит два типа токсинов: церулид и диарею. Каждый тип токсина имеет специфические эффекты.
Желудочно-кишечные инфекции, которые производит эта бактерия:
Рвотный синдромэто вызвано токсином cereulida и произведено приемом пищи, загрязненной этим. Его инкубационный период составляет от 1 до 5 часов..
Синдром диареиэто вызвано проглатыванием спор, которые впоследствии развиваются в тонкой кишке. Инкубационный период от 1 до 24 часов..
На уровне глазного яблока бактерия генерирует следующие инфекции:
кератит: инфекция наружного слоя глаза, роговицы.
панофтальмит: воспаление, которое затрагивает все структуры глаза. Это также может повлиять на структуры, окружающие его.
эндофтальмиты: инфекция, которая вредит всем слоям глаза. Это ограничено только этим.
Симптомы, вызванные Bacillis cereus
Рвотный синдром
Синдром диареи
- Обильная водянистая диарея
- Боль в животе
- Ректальный тенезм.
Иногда может быть лихорадка.
кератит
- Боль в глазах
- Слезотечение или выделения
- Прогрессирующая потеря зрения
- Чрезмерная чувствительность к свету.
панофтальмит
- головная боль
- Пери орбитальная боль
- покраснение
- припухлость.
эндофтальмиты
- Снижение зрения
- Отек вокруг глаз
- Боль в глазах
- Покраснение склеры
- Чувствительность к свету.
Важно быть внимательным к любым из этих симптомов, чтобы своевременно их лечить. Прогрессирование этих инфекций может привести к долговременным долгосрочным последствиям, а также к судьбе, особенно когда они развиваются у детей..
Bacillus cereus в еде
Хотя это не единственный возбудитель, передающийся через пищу, B. cereus Он ответственен за большинство вспышек заболеваний, передающихся при приеме пищи. В последние десятилетия общее число этих заболеваний имеет тенденцию к росту во всем мире..
Заболевание, известное как синдром жареного риса, является рвотным синдромом, вызываемым B. cereus. Обычная причина - вареный рис, который долгое время хранился при комнатной температуре, а затем быстро обжаривался перед подачей на стол..
Bacillus cereus Он является третьим ответственным за заболевания, вызванные загрязненным мясом, после стафилококков и сальмонеллы. Бактерия также присутствует в некоторых специях, поэтому ее употребление в мясо увеличивает риск отравления.
Сырое молоко может быть загрязнено B. cereus. Поскольку его споры противостоят пастеризации, он также может присутствовать в пастеризованном молоке и различных молочных продуктах..
Другие продукты, которые были обнаружены загрязненными B. cereus включают смеси для десертов, детского питания, полуфабрикатов, морепродуктов, какао, шоколада, бобовых, свежих овощей, круп и их производных.
Bacillus cereus у детей
В. cereus - название бактерий и болезней, которые ими вызваны. Инфекционный процесс может быть либо локализированным либо генерализированным. Чаще всего болезнь проходит как острый гастроэнтерит.
В группе риска находятся новорожденные, ослабленные, дети с иммунодефицитными состояниями, а также больные со злокачественными новообразованиями. В таких случаях Bacillus cereus сопровождается упорной бактериемией и нередко принимает форму сепсиса.
Эпидемиология. Бактерии рода Bacillus распространены во всех странах. Они «проживают» в почве, воздухе, на окружающих предметах и в воде. Инфекцию можно подхватить из пищевых продуктов, мединструментов, медаппаратуры, которые применяются для инвазивных лечений и исследований (клапанная аппаратура, системы для гемодиализа, катетеры и пр.). Пути передачи Bacillus cereus: алиментарный, контактный. Заболеваемость имеет спорадический характер (отдельные, не связанные, периодические случаи), но вспышки острого гастроэнтерита могут возникать при пищевом инфицировании.
Что провоцирует / Причины Bacillus cereus у детей:
В. census относятся к роду Bacillus. Они имеют палочковидную форму. Размер бактерий 2,2х 1,2—7 мкм, они подвижны, обладают имеют латерально расположенными жгутиками. По Граму окрашиваются положительно. Относятся к строгим аэробам, формируют эндоспоры. Bacillus подразделяются на 3 морфологические группы в зависимости от формы и раздувания клетки при спорообразовании. Возбудители болезни у детей, взрослых и животных относятся в основном к первой группе.
На данный момент науке известно примерно 20 серотипов данной бактерии. Их нельзя убить широко распространенными, традиционными дезинфицирующими растворами и препаратами.
В. cereus производят гемолизин, сходный со стрептолизином С, протсолитические ферменты, фосфолипазы, пенициллипазу, лецитиназу и пр.
Патогенез (что происходит?) во время Bacillus cereus у детей:
Инфекция проникает в организм черед ротоглотку, дыхательные пути или повреждения на коже. Большую роль играют инвазивные операции: ввод катетеров, клапанных аппаратов, шунтов, подключение системы гемодиализа и т. д. Такими путями В. cereus может попадать в кровь в большом количестве, находясь на инструментарии, перечисленном выше.
Если путь заражения алиментарный, данные бактерии приводят к острому гастроэнтериту. Энтеротоксин при этом приводит к поражению желудочно-кишечного тракта. Он же стимулирует систему циклических пуклеотидов в эпителиальных клетках тонкой кишки, вызывает повреждение слизистой оболочки желудка и тонкой кишки и нарушение сосудистой проницаемости. Из-за этого появляются такие симптомы как рвота и диарея.
От количества выработанного В. cereus пиогенного токсина зависит степень тяжести поражения ЖКТ и других органов. Данный токсин вызывает изъязвление эпителия дыхательных путей, деструкцию слизистой оболочки кишечника, абсцедирование (в том числе и ткани головного мозга).
Пищевое отравление В. cereus заканчивается благоприятно по причине локализации процесса. Инфекция, вызванная В. cereus, становится септической (и наблюдается упорная бактериемия) у ослабленных стрессами или иммунодефицитами детей, а также у новорожденных. В этих случаях морфологические изменения в органах (кишечник, легкие, мозг) выражаются в появлении острых воспалительных очагов с зонами некроза, фибриноидным некрозом артерий, в которых выявляются большие скопления В. cereus.
Симптомы Bacillus cereus у детей:
Инфекционный процесс, к которому приводят рассматриваемые бактерии, может проявляться разными симптомами. Пищевое отравление «выливается» острым гастроэнтеритом. При иных путях заражения наблюдается развитие менингита, бронхопневмонии, остеомиелита, абсцесса мозга, панофтальмита, эндокардит, сепсиса, бактериемии.
Инкубационный период при остром гастроэнтерите составляет от 1 до 16 часов. Болезнь имеет острое начало, ребенка тошнит, он жалуется на боли в животе. Повышения температуры обычно нет. Появляется рвота (возможно - многократная), а через несколько часов отмечают водянистую диарею. Отмечаются болезненные позывы на дефекацию («в туалет»). В некоторых случаях болезнь может проходить по аналогии с пищевой токсикоинфекции. Тогда, прежде всего, появляется профузная рвота, а диареи нет.
Острый гастроэнтерит может проходить в легкой или среднетяжелой форме. Тяжелые формы - очень большая редкость. Болезнь может длиться как несколько часов, так и 2 суток.
Пневмония, вызванная Bacillus cereus, начинается остро - появляется лихорадка и одышка. Появляются боли в области грудины. Рентген показывается Рентгенологически выявляется одно- или двусторонний инфильтративный процесс с поражением одной или нескольких долей легкого и вовлечением плевры. Пневмония может быть геморрагической, в таком случаи часты летальные исходы.
Менингит имеет острое начало, температура очень высокая, рвота повторная, развиваются менингеальные симптомы, повторные судороги. Состояние больного ребенка тяжелое. В спинномозговой жидкости обнаруживают значительный плеоцитоз, а лимфоциты и нейтрофилы наличествуют в равном количестве. В периферической крови может быть лейкоцитоз с нейтрофильным сдвигом. Симптомы проявляются довольно долго, не помогают препараты пенициллинового ряда.
Септицемия. Инфекционный процесс, вызванный Bacillus cereus, может проявляться септицемией с очагами воспаления или без них. Показательный симптом - упорная лихорадка, которая становится интермиттирующей (перемежающейся). Источник инфекции удается установиться не всегда (как и «входные ворота»). При данной форме инфекции В. cereus выделяется в чистой культуре.
Диагностика Bacillus cereus у детей:
Для точного диагноза используют только выделение возбудителя из биологического материала от заболевшего ребенка и доказательство патогенности выделенных бактерий. Для анализа используют кровь, рвотные массы, мокроту, мочу, испражнения, отделяемое из очага воспаления (гной, слизь). Диагностическое значение имеет большое количество бактерий при остром гастроэнтерите. При других поражениях необходимо получить высев микроба в повторных порциях крови.
Поскольку по клиническим проявлениям инфекцию, вызванную В. cereus, невозможно отличить от других инфекций, решающее значение придается повторному обнаружению В. cereus в больших количествах в материале от больного при отсутствии выделения других микроорганизмов. Однако необходимо учитывать, что В. cereus может вызывать патологический процесс совместно с другими инфекционными агентами, например, с протеем или эшерихиями.
Лечение Bacillus cereus у детей:
Острый гастроэнтерит, вызванный В. cereus, лечится назначением соответствующей диеты и оральной регидратации. Под регидратацией понимают восполнение обычного водного баланса в организме.
Тяжелые процессы (менингит, бронхопневмония, септицемия, остеомиелит) требуют назначение антибиотиков. В. cereus благодаря выработке р-лактамазы, устойчивы к пенициллину и препаратам на его основе. Но их можно уничтожить цефалослоринами 3-го и 4-го поколений.
Антибиотики применяют в дозах, соответствующих возрасту. Срок лечения составляет от 5 до 10 суток. Отменяют прием антибиотиков после санации от возбудителя, прихода в нормы температуры тема и ликвидации симптомов.
Применяют для лечения также колибактерин. Это препарат с антибактериальным и противодиарейным действием, он восстанавливает кишечную микрофлору и иммунную систему, борется с патогенными и условно-патогенными нефизиологичными микроорганизмами.
Профилактика Bacillus cereus у детей:
Специфической профилактики данной инфекции на данный момент не разработано. Следует предупредить попадание В. cereus на предметы ухода за новорожденными и ослабленными детьми, а также на медицинские инструменты, особенно те, которые используются для инвазивных методов лечения и обследования детей и взрослых.
Профилактика острого гастроэнтерита заключается в соблюдении элементарных гигиенических правил и полноценной термической обработке пищевых продуктов.
К каким докторам следует обращаться если у Вас Bacillus cereus у детей:
Вас что-то беспокоит? Вы хотите узнать более детальную информацию о Bacillus cereus у детей, ее причинах, симптомах, методах лечения и профилактики, ходе течения болезни и соблюдении диеты после нее? Или же Вам необходим осмотр? Вы можете записаться на прием к доктору .
Общая характеристика бацилл, таксономия, морфология, филогения
бацилла это род бактерий, относящихся к отряду Bacillales, классу Bacilli, типу Firmicutes. Этот род группирует большое разнообразие бактерий, которые имеют общую характеристику способности производить эндоспоры, неактивные в аэробных условиях, при воздействии среды с неблагоприятными условиями..
Эти эндоспоры устойчивы к теплу, радиации, дезинфицирующим средствам и высыханию, поэтому виды бацилла могут быть проблемными загрязнителями в больничных условиях, в фармацевтических продуктах и в продуктах питания.
![]()
- 1 Являются ли они патогенными?
- 2 Где они??
- 3 Характеристики
- 4 Морфология
- 5 Филогения
- 6 Жизненный цикл
- 6.1 Неблагоприятные условия
- 6.2 Латентные споры ступенчато-вегетативных клеток
Являются ли они патогенными?
Большинство видов бацилла они не являются патогенными и редко связаны с болезнями людей или других животных.
Самые известные исключения Bacillus anthracis, возбудитель сибирской язвы, Bacillus thuringiensis, патогенный для беспозвоночных, Bacillus licheniformis, участвует в пищевых отравлениях и других инфекциях человека и животных, и Bacillus cereus, причина пищевых отравлений и оппортунистических инфекций.
Где они?
Бактерии рода бацилла они были изолированы в основном в почве, воде, продуктах питания и клинических образцах. Но они также были обнаружены в самых необычных средах, таких как океанические отложения на тысячи метров ниже уровня моря и в образцах стратосферного воздуха, в кислых геотермальных бассейнах, в сильнощелочных грунтовых водах и в терминальных гиперсолевых озерах..
Другие были обнаружены в нишах, созданных людьми, от мексиканских гробниц и испорченных римских настенных росписей, до ультрачистых помещений на объектах по сборке космических кораблей..
Растения также являются богатым источником новых видов бацилла, некоторые эндофитные и другие, связанные с ризосферой.
-Большое разнообразие бактерий, входящих в род бацилла может быть грамположительным (только на ранних стадиях роста) или грамотрицательным, подвижным с перитрихозными или неподвижными жгутиками, аэробными, факультативными анаэробными или строго анаэробными.
-Они обладают большим разнообразием физиологических способностей, от психрофильных до термофильных, от ацидофильных до алкалофильных. Некоторые штаммы являются галофильными.
-Большинство видов производят каталазу и могут быть как оксидазой, так и негативом..
-Они хемореганотрофны. Два вида являются факультативными хемолитотрофами, то есть они получают свою энергию от окисления восстановленных неорганических соединений, таких как аммиак, элементарная сера, водород, ионы железа, нитрит и сера. Эти организмы могут получать весь свой клеточный углерод из углекислого газа и могут расти без каких-либо органических соединений и без света..
Бактерии рода бацилла они могут быть палочковидными, прямыми или слегка изогнутыми, обычно круглыми, хотя некоторые ячейки были описаны как квадратные (например,. Bacillus cereus).
Ячейки имеют диаметр от 0,4 до 1,8 мкм и длину от 0,9 до 10,0 мкм. Размеры клеток в пределах каждого вида и в каждом штамме обычно имеют небольшую изменчивость.
Клетки встречаются индивидуально и парами, некоторые в цепочках и иногда в длинных нитях. В зависимости от вида, штамма и условий культивирования дочерние клетки могут быть разделены.
Таким образом, культура, по-видимому, состоит из отдельных клеток и пар делящихся клеток при наблюдении с помощью фазово-контрастной микроскопии. В других случаях дочерние клетки могут оставаться прикрепленными друг к другу, поэтому вы видите цепочки клеток.
Морфология спор является таксономической особенностью, хотя могут быть некоторые различия в определенных штаммах. Наиболее распространенные споры имеют эллипсоидальную или овальную форму, но формы варьируются от цилиндрических до эллипсоидальных, сферических или неправильных форм, которые напоминают почку или банан.
филогения
Изначально жанр бацилла был описан для палочковидных бактерий, обладающих способностью аэробно производить рефрактильные эндоспоры, с большей устойчивостью к теплу, влаге и другим разрушающим агентам, чем вегетативные клетки.
Однако, когда новые инструменты молекулярной таксономии были применены к жанру, полученные данные поставили под сомнение существующую парадигму, согласно которой род состоит из небольшого числа видов, которые можно строго идентифицировать по определенным фенотипическим признакам..
В 1991 году было показано, что на самом деле в одном жанре было шесть разных групп, что привело к созданию пяти новых жанров. В результате систематика старого стиля бацилла был радикально преобразован.
В настоящее время известно более 142 видов рода. бацилла, Однако в период между 2004 и 2006 годами новые виды бацилла в среднем один раз в неделю, поэтому считается, что это число может быть намного выше.
Жизненный цикл
При адекватных условиях питания, температуре, pH, составе атмосферы, среди прочего, клетки бацилла они растут и делятся путем деления на две части - формы бесполого размножения, которая заключается в дублировании ДНК с последующим делением цитоплазмы разделительной стенкой, которая пересекает центр клетки, давая начало двум дочерним клеткам.
Неблагоприятные условия
Однако, когда условия окружающей среды неблагоприятны, вегетативные клетки генерируют эндоспоры, которые представляют собой клеточные структуры, не содержащие АТФ и обладающие чрезвычайно скрытым метаболизмом, что придает ему устойчивость..
Эндоспоры образуются в конце фазы экспоненциального роста. Известны многие другие факторы, которые влияют на образование эндоспор, такие как температура роста, рН окружающей среды, аэрация, присутствие определенных минералов и источников углерода, азота и фосфора и их концентрации. Другое влияние - плотность населения..
Ступени латентных спор-вегетативных клеток
Преобразование латентных спор в вегетативные клетки включает три этапа: активация, прорастание и внешний рост. Бездействие нарушается при благоприятных изменениях температуры или старении клеток..
Однако многие виды не требуют такой активации. При выходе из латентного периода, если спора находит подходящие условия окружающей среды, прорастание инициируется из-за потери преломления, быстрого гидролиза коры и разложения небольших растворимых кислотных белков, которые придают устойчивость к агентам. химический и радиационный.
Протопласт проросших спор заметно набухает из-за поглощения воды, биосинтез возобновляется, и из слоя спор ротама выходит новая вегетативная клетка, что приводит к новому вегетативному периоду размножения.
Bacillus subtilis таксономия, характеристика, морфология, заболевания
Bacillus subtilis Это положительная каталазная бактерия, которая широко распространена по всему миру. Это один из экземпляров рода бацилла наиболее изученный.
Обычно, когда люди слышат о бактериях, они воображают болезнетворные патогены. Однако эти микроорганизмы не всегда наносят ущерб своему хозяину. Некоторые бактерии способны приносить пользу не только для людей, но и для окружающей среды..
![]()
Это случай Basillus subtilis, Грамположительные бактерии, которые сообщают об огромных преимуществах в нескольких и разнообразных областях. В течение многих лет биохимические свойства этой бактерии были изучены.
Таким образом, был сделан вывод, что он безвреден для человека, так как он не причиняет никакого вреда, будучи в контакте с ним. В редких случаях были описаны некоторые вредные воздействия, но это было определено другими аспектами, помимо патогенности бактерий как таковых..
Напротив, многие доказанные преимущества этой бактерии, будь то в сельском хозяйстве, медицине или промышленности, сделали ее одним из лучших вариантов, когда речь заходит о выявлении положительного эффекта определенных бактерий для человечества..
- 1 Таксономия
- 2 Морфология
- 3 Общие характеристики
- 4 Связанные патологии
- 5 Клиническая картина
- 6 Применение Bacillus subtilis
- 6.1 Противогрибковая активность
- 6.2 Разработка моющих средств
- 6.3 В фармакологической области
- 6.4 В гастрономии
таксономия
Таксономическая классификация бактерий Bacillus subtilis Это следующее:
домен: бактерия
Фил: Firmicutes
семья: Baacillaceae
жанр: бацилла
вид: Bacillus subtilis
Как и все, принадлежащие к этому роду, клетки Bacillus subtillis Они имеют форму бара с закругленными краями. Они имеют ширину около 1 микрона и длину 2-3 микрона. Они найдены индивидуально или образуют небольшие цепочки.
При наблюдении под микроскопом в центре бактериальной клетки видна сферическая спора, которая не изменяет форму бактерии..
В культурах с кровяным агаром они образуют колонии, которые могут выглядеть гладкими, грубыми или слизистыми. Его края могут быть вытянуты посередине или быть волнистыми.
Аналогично, средний размер колоний составляет от 2 до 4 мм в диаметре..
Бактериальная клетка имеет толстую клеточную стенку, состоящую из пептидогликана, известного как мурейн.
Что касается генома, бактерия имеет одну круговую хромосому, которая содержит 4100 генов, которые кодируют экспрессию определенных белков.
От поверхности клетки вытягиваются выпячивания, жгутики. Это способствует мобильности клетки.
Общие характеристики
При воздействии процесса окрашивания по Граму бактерия приобретает типичную фиолетовую окраску грамположительных бактерий. Это связано с наличием пептидогликана в клеточной стенке.
С другой стороны, когда бактерии растут на кровяном агаре, наблюдается закономерность полного гемолиза. Это помещает их в группу бета-гемолитических бактерий, способных вызывать полный лизис эритроцитов.
Что касается обмена веществ, то Bacillus subtilis способен гидролизовать триглицериды, но не фосфолипиды или казеин.
До недавнего времени считалось, что эта бактерия была строго аэробной. Тем не менее, недавние исследования показали, что он может выживать в условиях отсутствия кислорода. В анаэробных условиях ферментация может осуществляться по бутандиольному пути. Вы также можете выполнить аммонификацию с нитратом.
Bacillus subtilis Это бактериальный вид, который можно найти в разных средах. Он был изолирован от наземных и водных сред. Однако, когда вы находитесь в среде с враждебными условиями, у вас есть механизм, чтобы выжить.
![]()
Этот механизм - производство спор, которые очень устойчивы к изменению условий внешней среды. Как только среда снова становится благоприятной, споры прорастают, и бактерии снова начинают размножаться.
Среди его атрибутов можно отметить, что он представляет собой фермент каталазы, который позволяет ему разделить молекулу перекиси водорода на составляющие: воду и кислород.
Другими важными ферментами являются нитратредуктазы, особенно два, которые являются уникальными. Один из них используется для усвоения нитрата водорода, а другой - для дыхания нитрата..
Что касается экологических требований, то Basillus subtilis он может расти и развиваться в диапазоне температур от 15 ° C до 55 ° C. Он также способен выживать при концентрации соли до 7% NaCl..
Родственные патологии
Bacillus subtilis Это бактерия, которая считается безопасной и безвредной для человека. Однако, поскольку он обнаружен в почве и в кишечнике некоторых животных, возможно, он заражает некоторые продукты питания..
Клиническая картина
В немногих случаях пищевого отравления Bacillus subtilis, описанные симптомы похожи на отравление, вызываемое бактериями Bacillus cereus. Среди самых выдающихся можно выделить:
- понос
- тошнит
- общее недомогание
- Общее недомогание.
Важно отметить, что это единичные случаи, настолько скудные, что литературы по ним мало.
Как правило, и на основе исследований, которые были проведены с использованием Bacillus subtilis, утверждается, что это безвредная бактерия для человека.
Приложения из Bacillus subtilis
Bacillus subtilis Это бактерия, которая была полезна в нескольких областях или областях. Исследования все еще продолжаются, чтобы определить полезность.
Противогрибковая активность
Среди патогенных микроорганизмов, поражающих различные культуры, есть грибы. Они являются одними из основных причин повреждения и порчи некоторых растений.
В экспериментальных исследованиях удалось определить противогрибковый эффект Bacillus subtilis. Высвобождает определенные вещества, которые способны разрушать клеточные стенки других организмов, например грибов, вызывая их лизис.
Принимая во внимание эту характеристику, Bacillus subtilis Широко используется для борьбы с вредителями в посевах.
Производство моющих средств
Bacillus subtilis производит тип ферментов, известных как протеазы, которые использовались в течение многих лет в качестве добавок в моющих средствах. Среди протеаз, продуцируемых этой бактерией, наиболее широко применяемым в промышленности при производстве моющих средств является субтилизин..
![]()
Полезность этих ферментов заключается в том, что они способны разлагать вещества белкового происхождения, что выражается в эффективности моющего средства в устранении этого типа пятен.
В фармакологической области
Bacillus subtilis производит определенные вещества, которые оказывают антибиотическое действие. Это означает, что они способны устранять другие штаммы бактерий, которые являются патогенными.
Примером этого является препарат бацитрацин, который представляет собой мазь, которая наносится на раны, раны или ожоги и эффективна против других грамположительных бактерий. Бацитрацин состоит из полипептидов, продуцируемых одним из штаммов, выделенных из этого вида бактерий..
Аналогично, эта бактерия производит приблизительно два десятка веществ с антибиотическими свойствами, которые включают пептиды синтеза рибосом и другие, которые не являются таковыми..
Это вещества, действие которых до сих пор изучается для определения всех их возможностей..
В гастрономии
Есть напряжение Bacillus subtilis который воздействует на семена сои, осуществляя процесс ферментации. Результатом этого процесса является еда японского происхождения, известная под названием Натто.
Это еда с необычным вкусом, но она компенсируется большим количеством питательных веществ, которые она обеспечивает..
Bacillus subtilis Это бактерия, известная большим количеством преимуществ, которые она приносит человеку. Несмотря на это, есть еще много его свойств, чтобы обнаружить. Это микроорганизм, который даст много говорить о биотехнологии.
Читайте также: